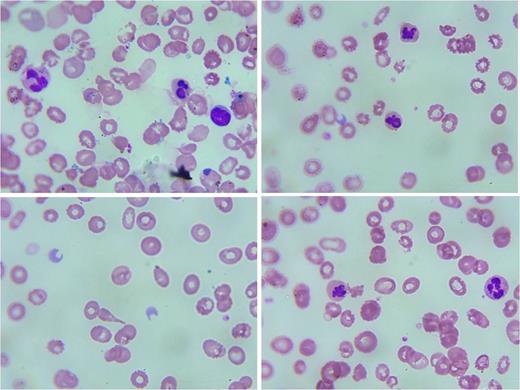

Abstract
Introduction
The congenital dyserythropoietic anaemias (CDA) are a rare group of inherited haemolytic anaemias characterized by ineffective erythropoiesis and dyserythropoiesis. Due to the rarity of this disorder (and in Africa where haemoglobinopathies are the commonest cause of congenital haemolytic anaemias), the diagnosis can be missed. We report a six year old girl with recurrent anaemia, jaundice, hepatosplenomegaly and history of multiple transfusions who was diagnosed with CDA.
Case Report
A six year old girl presented to the paediatric clinic with a two year history of passing coke-coloured urine, recurrent anaemia requiring regular three-monthly transfusions and persistent jaundice. She was not a known sickle cell anaemia or thalassaemia patient. History of prenatal period, birth and delivery were normal (birth weight 3.5kg/ 7.7lbs). There was no history of neonatal jaundice or family history of similar illness.
At presentation, she was acutely ill-looking, conscious but weak. She was afebrile, severely pale, icteric, tachypneic and in respiratory distress (respiratory rate of 52 cycles/minute). She was small for age; weight 15kg / 33.1lbs (below the 3rd percentile), height 104cm (below the 3rd percentile) with frontal bossing and gnathopathy. The liver was 6cm below the right costal margin and tender, with splenomegaly- 5cm below the costal margin. There was no lymphadenopathy. Her chest was clear, heart rate 140 beats/minute, and blood pressure of 100/50mmHg with presence of a haemic murmur. A preliminary clinical diagnosis of recurrent severe haemolytic anaemia in heart failure secondary to haemoglobinopathy was made.
Full blood count showed severe anaemia with haemoglobin (Hb) concentration of 5.1g/dL, normal red cell indices, white cell count- 13.6 X 109/L, platelets- 191 X 109/L and reticulocyte count- 1.3%. The Hb genotype was AA, direct and indirect antiglobulin test were negative. Liver functions tests showed normal enzyme and protein values; but high total bilirubin (104mmol/L) and unconjugated bilirubin- 17.4umol/L. Serum uric acid was normal. HIV, hepatitis B and C were negative. Urinalysis was positive for blood, urobilinogen, bilirubin, with a pH of 8.0. Urine microscopy showed granular, epithelial and red blood cell casts. Glucose-6-phosphate dehydrogenase assay- 12.5 μ/Hb.
She was admitted, placed on oxygen, transfused and discharged on the third day in stable condition. However she was brought back to the hospital about 3 months later for similar symptoms. Urgent Hb concentration was 6.0g/dL. Peripheral blood film revealed anisopoikilocytosis, some macrocytes, tear drop cells, polychromasia, basophilic stippling, fragmented red cells and presence of nucleated red cells (12/100 white cells)- a few of which were multinucleated (Fig 1). HPLC showed low HbA (74.1%), severely increased HbF (23.8%) and HbA2 (2.1%). Bone marrow (BM) aspiration showed a hypercellular marrow, erythroid hyperplasia (myeloid/erythroid ratio 1:2), dyserythropoiesis with erythroid multinuclearity in >10% of late erythroid precursors and significant karyorrhexis. Myelopoiesis and megakaryopoiesis were essentially normal (Fig 2). Serum ferritin was elevated (2,658ng/ml). In the absence of availability of electron microscopy or molecular studies, a diagnosis of CDA type II was made based on clinical, laboratory and characteristic bone marrow findings. She was transfused, placed on iron chelation therapy, her parents counseled on treatment options and she is being followed up.
Discussion
The CDAs are classically grouped into 3 types based on bone marrow morphology. Type I has erythroblasts joined by an internuclear bridge. Type II erythroblasts have multinuclearity of late erythroblasts while type III has gigantoblasts (erythroblasts with ≥8 nuclei). Inheritance is autosomal recessive and diagnosis is usually in childhood or early adult life. Common clinical findings are anaemia, jaundice and splenomegaly; however these are seen in other more common inherited haemolytic anaemias. BM examination is the gold standard for diagnosis. Patients with CDA usually have high serum ferritin that may require iron chelation therapy.
CDA although rare must be considered in a child who has recurrent anaemia in whom other causes have been excluded. BM examination remains a key diagnostic tool in identification of the CDAs.
Blood Film
Bone Marrow
No relevant conflicts of interest to declare.
Author notes
Asterisk with author names denotes non-ASH members.

This feature is available to Subscribers Only
Sign In or Create an Account Close Modal